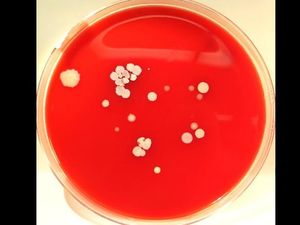
Dianggap Menjijikkan, Foto Ini Dorong Petugas Kesehatan Rajin Cuci Tangan
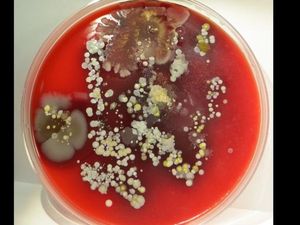
Gambar Ini Bikin Petugas Kesehatan Rajin Cuci Tangan, Bagaimana dengan Anda?

detikHealthSenin, 21 Nov 2016 09:05 WIB
detikHealthSenin, 21 Nov 2016 09:05 WIB
Berapa Lama Waktu yang Dianjurkan untuk Mencuci Tangan? Ini Kata Pakar
Agar manfaat dari mencuci tangan jadi efektif, ada waktu minimal yang dianjurkan para ahli. Berapa lama ya?
 detikHealthSenin, 21 Nov 2016 09:05 WIB
detikHealthSenin, 21 Nov 2016 09:05 WIB
Agar manfaat dari mencuci tangan jadi efektif, ada waktu minimal yang dianjurkan para ahli. Berapa lama ya?
 detikHealthSenin, 17 Okt 2016 19:02 WIB
detikHealthSenin, 17 Okt 2016 19:02 WIB
Jeriken berkeran ada di depan rumah beberapa rumah warga daerah ini. Jeriken ini sengaja ditaruh untuk menggalakkan kebiasaan cuci tangan pakai sabun.
 detikNewsSabtu, 15 Okt 2016 11:27 WIB
detikNewsSabtu, 15 Okt 2016 11:27 WIB
Ratusan anak-anak berbaju hijau memadati RPTRA Meruya Utara, Jakarta Barat. Mereka mengikuti Hari Cuci Tangan Sedunia yang diperingati hari ini.
detikHealthSenin, 13 Jun 2016 08:04 WIB
detikHealthSenin, 13 Jun 2016 08:04 WIB
Ada aneka cara membangkitan motivasi seseorang untuk mencuci tangan pakai sabun. Salah satunya dengan memperlihatkan foto-foto bakteri di aneka permukaan benda.
detikHealthSenin, 13 Jun 2016 07:14 WIB
detikHealthSenin, 13 Jun 2016 07:14 WIB
Setelah diperlihatkan gambar ini, para petugas kesehatan jadi lebih rajin cuci tangan pakai sabun. Wah, gambar apa ya?
 detikHealthMinggu, 01 Mei 2016 11:01 WIB
detikHealthMinggu, 01 Mei 2016 11:01 WIB
Hendak mencuci tangan tapi kebetulan memakai cincin, sebaiknya lepas dulu cincin Anda. Apa alasannya?
 detikFoodJumat, 22 Apr 2016 17:08 WIB
detikFoodJumat, 22 Apr 2016 17:08 WIB
Sakit setelah konsumsi makanan bisa disebabkan karena kontaminasi. Untuk menghindarinya, Anda perlu memperhatikan proses pengolahan makanan yang baik.
 detikHealthKamis, 14 Apr 2016 08:39 WIB
detikHealthKamis, 14 Apr 2016 08:39 WIB
Cuci tangan memang ampuh untuk menghilangkan kuman, namun salah cara mengeringkannya bisa jadi justru 'menarik' kuman datang kembali.
 detikHealthSenin, 21 Mar 2016 17:06 WIB
detikHealthSenin, 21 Mar 2016 17:06 WIB
Lingkungan yang kotor meningkatkan risiko terserang berbagai penyakit infeksi. Untuk menghindarinya, jangan lupa selalu mencuci tangan pakai sabun.
 WolipopKamis, 28 Jan 2016 11:16 WIB
WolipopKamis, 28 Jan 2016 11:16 WIB
Hand sanitizer menjadi salah satu alternatif ketika tidak tersedia air maupun sabun untuk mencuci tangan. Tapi bisakah menjadi pengganti sabun seterusnya?